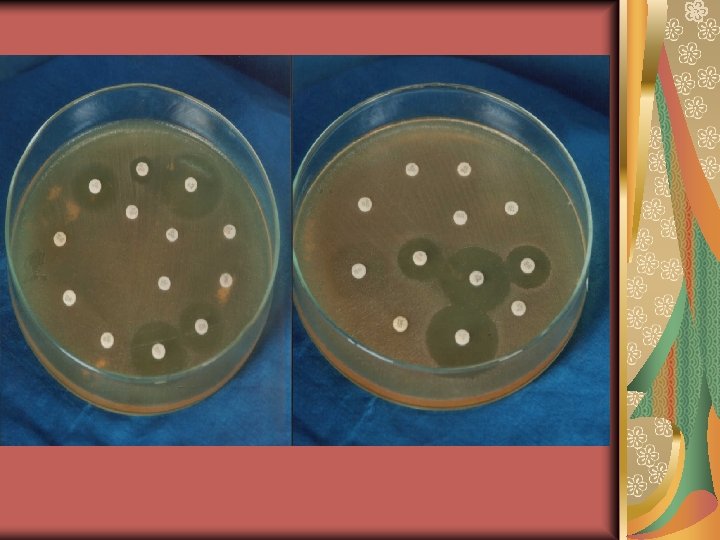
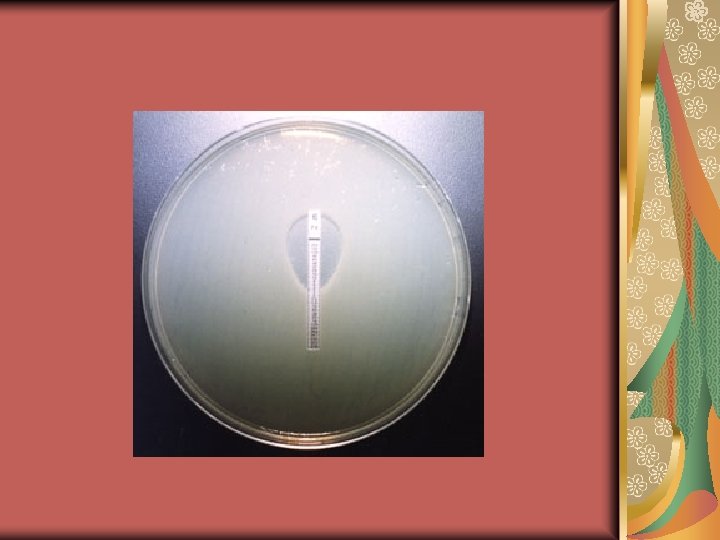

Antimicrobial Chemotherapy Learning Objectives Definitions Mechanisms of antibiotic

Antimicrobial Chemotherapy

Learning Objectives Definitions Mechanisms of antibiotic action Antibiotic susceptibility Methods of administration Complications of antibiotic use Resistance to antimicrobials

HISTORY - Antibiotics revolutionised medicine - The first antibiotic, penicillin, was discovered by Alexander Fleming in 1929 - It was later isolated by Florey and Chain - It was not extensively used until the 2 nd World War when it was used to treat war wounds - After 2 nd World War many more antibiotics were developed - Today about 150 types are used © 2008 Paul Billiet ODWS

Definitions Antimicrobial chemotherapeutic agents: are chemically synthesized substances that are used to treat infectious diseases by killing or inhibiting the growth (or multiplication) of microorganisms. Antibiotics: are low-molecular weight antimicrobial substances that are produced as secondary metabolites by certain groups of microorganisms, especially Streptomyces, Bacillus, and a few moulds (Penicillium and Cephalosporium). Some antibiotics are currently made synthetically (synthetic antibiotics).

Bacteriostatic agent: is an antimicrobial agent that is capable of inhibiting bacterial multiplication. Multiplication resumes upon removal of the agent. Bactericidal agent: is an antimicrobial agent that is capable of killing bacteria. Multiplication can not be resumed. Selective toxicity: is the ability of an antimicrobial agent to harm a pathogen without harming the host. It may be a function of a specific receptor (or target) for the drug found in the microbe but not in the human body (e. g. peptidoglycan), or it may depend on the inhibition of a biochemical event essential for the organism but not for the host.

Spectrum of activity: the range of microorganisms that are affected by a certain antibiotic is expressed as its spectrum of action. Antibiotics which kill or inhibit the growth of a wide range of Gram-positive and Gram-negative bacteria are said to be broad spectrum. If effective mainly against either Grampositive or Gram-negative bacteria, they are narrow spectrum. If effective against a single organism or disease, they are referred to as limited spectrum.

Mechanisms of Action of Antimicrobials A- Inhibition of bacterial cell wall synthesis Agents acting by this mechanism include: β-lactam antibiotics: e. g. penicillins, cephalosporins, and others. Glycopeptides: e. g. vancomycin, and teicoplanin. Cycloserine and bacitracin. These antibiotics are bactericidal with minimal tissue toxicity.

B- Interference with the cell membrane function Some agents disrupt the cytoplasmic membrane and interfere with its function. Theses include: Antibacterial agents: e. g. polymyxin and colistin. Antifungal agents: e. g. amphotericin B, nystatin and imidazoles. These agents are microbicidal. They are highly toxic as they have narrow margin of selective toxicity.

C- Inhibition of bacterial protein synthesis Bacteria have 70 S ribosomes (with 30 S and 50 S subunits) whereas mammalian cells have 80 S ribosomes (40 S and 60 S subunits): Agents acting on the 30 S ribosomal subunit: e. g. tetracycline and aminoglycosides (gentamicin, amikacin, streptomycin). Agents acting on the 50 S ribosomal subunit: e. g. macrolides (erythromycin, clarithromycin, azithromycin), lincomycins (clindamycin), streptogramins (quinupristin/dalfopristin), oxazolidinones (linezolid), chloramphenicol and fusidic acid.

D- Inhibition of bacterial nucleic acid synthesis This may occur by: Inhibition of RNA synthesis through the strong to DNA- dependent RNA polymerase: e. g. rifampin. Inhibition of DNA synthesis through blocking DNA gyrase: e. g. quinolones and novobiocin. Inhibition of dihydrofolic acid reductase leading to inhibition of folic acid synthesis. The latter is important for purine synthesis and, consequently, nucleic acid formation. Examples of these antimicrobials include trimethoprim and pyrimethamine.

E- Competitive antagonism e. g. sulphonamides For many organisms, para-amino benzoic acid (PABA) is essential for the synthesis of folic acid. Sulphonamides are structural analogues of PABA. They compete with PABA for the active centre of the enzyme involved in folic acid synthesis. As a result, nonfunctional analogues of folic acid are formed and nucleic acid synthesis is inhibited.

Summation A. Inhibition of bacterial cell wall synthesis B. Interference with the cell membrane function C. Inhibition of bacterial protein synthesis D. Inhibition of bacterial nucleic acid synthesis E. Competitive antagonism e. g. sulphonamides



In Vitro Microbial Susceptibilities to Antimicrobial Agents Microorganisms vary in their susceptibility to different chemotherapeutic agents, and susceptibilities can change over time.

The routine in vitro susceptibility testing can be done by one of the following methods: Disc diffusion methods. 2. Dilution methods such as tube broth dilution. 3. Gradient diffusion (E test) methods. 1.

COMLICATIONS OF CHEMOTHERAPY 1. Toxicity: may be dose-dependent or independent, e. g. : Tetracycline may cause staining of teeth in infants. Streptomycin may affect the 8 th cranial nerve leading to vestibular dysfunction. Aminoglycosides may cause nephrotoxicity. Chloramphenicol can cause bone marrow depression. 2. Allergy (hypersensitivity): usually not dose- dependent, e. g. : Penicillins may cause urticaria, anaphylactic shock or serum sickness. Local application of sulphonamides may result in contact dermatitis.

3. Emergence of resistant strains: The abuse of antibiotics (low dosage, interrupted course, no real indication, and improper choice) encourages the emergence of resistant mutants. These mutants will overgrow and replace the originally susceptible bacteria. 4. Superinfection: It occurs as a result of outgrowth of resistant members of normal flora when the sensitive ones are eradicated during antibiotic therapy e. g. : Pseudomembranous colitis caused by outgrowth of Clostridium difficile. Oral thrush caused by overgrowth of the yeast Candida.

RESISTANCE TO ANTIMICROBIAL AGENTS Antibiotic resistance is a global problem faced today in the treatment of infectious diseases. Resistance to antibiotics is more prevalent in hospitals especially intensive care units due to the higher antibiotic use. Resistance to antimicrobial agents is of two categories either intrinsic or acquired.

Antimicrobial Chemoprophylaxis is the administration of an effective antimicrobial agent to prevent infection with a certain microbe, thus preventing development of a disease. Prevention rather than treatment

Examples: Examples Long acting penicillin (or erythromycin): is given to rheumatic patients to prevent reinfection with S. pyogenes. Rifampicin: is given to close contacts of meningococcal meningitis for 2 days to prevent meningitis. Penicillin or erythromycin: is given to individuals with abnormal heart valves prior to dental procedures to prevent endocarditis. Preoperative in some surgical operations.


- Slides: 26